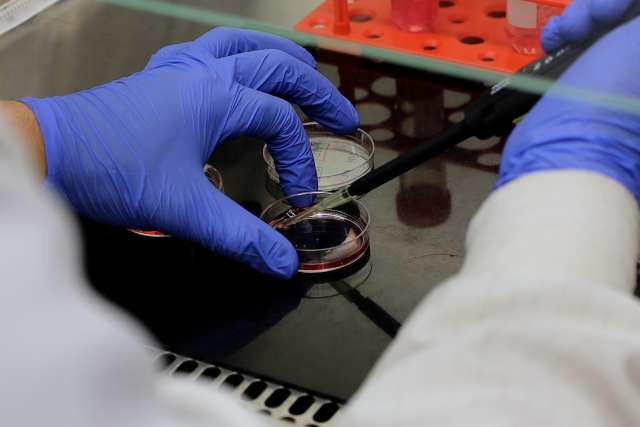
Lab members hands with petri dish

Neurology & Neuroscience Research
The UCLA Department of Neurology is committed to ongoing research in a quest to develop new treatments and cures for all neurological conditions.

Clinical and basic science research activities are ongoing in many subspecialty areas including Alzheimer's disease, epilepsy, multiple sclerosis, amyotrophic lateral sclerosis, neurorehabilitation (stroke and spinal cord injury), and post-polio.
Our faculty has been instrumental in making major breakthroughs, and some of our discoveries have revolutionized the diagnosis and treatment of neurological conditions, while others have improved upon breakthroughs made at other research facilities or academic medical centers.
The Department of Neurology’s research is respected worldwide and recognized by some of the largest federal and private granting institutions by awarding significant funding to further our ongoing research efforts.

Research Lab Profiles
Meet the brains behind UCLA Neurology! We spotlight faculty research labs that make up our department. You will hear directly from researchers about their novel work, cutting-edge methodology, and how their discoveries are being used to help those suffering from neurological disease.
Publications and Journals
UCLA Neurology faculty and trainees are at the forefront of novel research in the field. They are frequently published in neurology journals as well as featured in popular media.

Residency Research Development Track
Physician-scientists occupy a critical niche in the translation of basic science findings into new clinical treatments. UCLA Neurology has recognized our responsibility as a leading academic department to contribute to the scientific future by participation in the NIH-funded neurology residency research track, also know as the R25 program.
Find Research Faculty
Browse our directory of faculty, staff, and trainees at affiliated and partner sites.

Clinical Trials
UCLA Neurology supports many major research programs working to develop new treatments for a wide range of diseases. Clinical trials represent the final stage of cutting-edge science and medicine's pursuit of improved treatments.